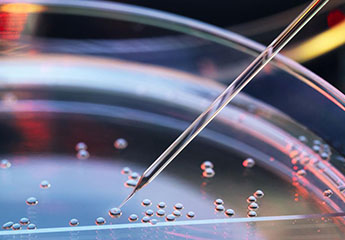

Advisory Services
Lorem ipsum dolor sit amet, eu qui modo expeten dis reformidans, ex sit appetere sententiae..
Read MoreThe Trans European Stem Cell Therapy Society (TESCT) was founded in 2005 by Dr. Marco Traub PHD in Switzerland to encourage the speedy transfer of stem cell technology from laboratory translation to clinical practice with the focus on the patient and the improvement of the Life Quality
TESCTS concerns about the unsustainabiity of health systems in Europe.An ageing, co-morbid population needs attention with a clear focus on the role of prevention. We are joined partner to “Patient and citizen Empowerment across the EIP Action”, A1.
CRISPR-Cas9 was first described as a gene editing tool in 2012.In just a few years, the technology has..
Read More
The brain- the most complex organ of mankind and the challenge to understand its function and to cure its disorders..
Read More
Adipose derived stem cells for clinical usage.Stem cell therapies applicable for fertilization technologies..
Read More
The Trans European Stem Cell Therapy Society (TESCT) was founded in 2005 by Dr. Marco Traub PHD in Switzerland to encourage the speedy transfer of stem cell technology from laboratory translation to clinical practice with the focus on the patient and the improvement of the Life Quality. Together with Rosie Graham from London the TESCT Society was formed to an expert forum and arranged milestone meetings at the Royal Academy of Medicine London and the University of Dakar and University of Ljubljana and the European Commission, Brussels. Stakeholders from Science and Politics joined over the years such as Stephen Minger, Julia Polak, Marco Cappato and Mary Baker and many more.
About MoreCopyright © 2019 TESCT. Developed by BayState InfoTech.
